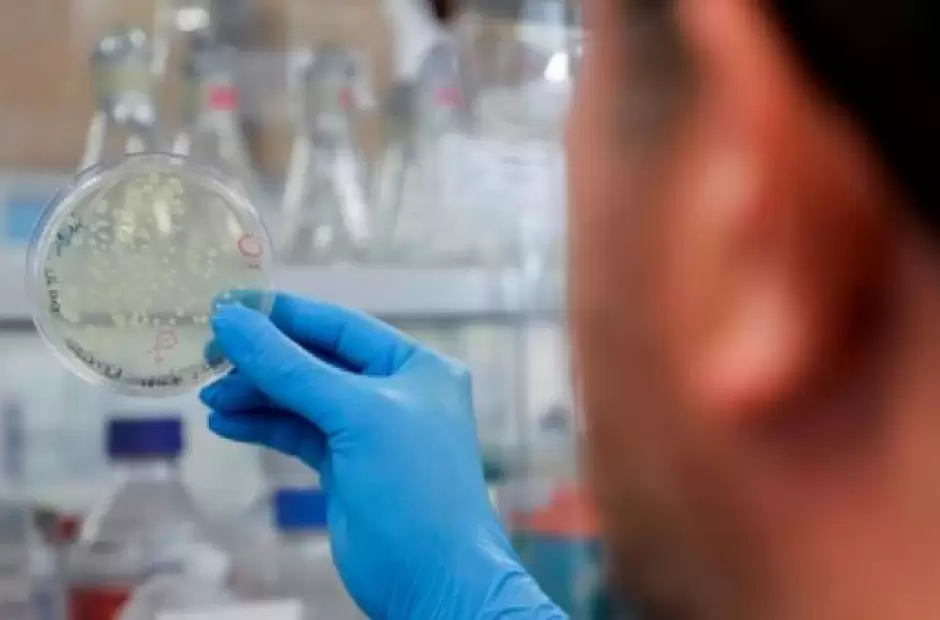

Mientras muchos países intentan sin éxito vacunar a la mayor parte de sus poblaciones para ganarle la carrera a las segundas olas de la pandemia en los diferentes territorios, un reciente hallazgo de la ciencia podría ser el puntapié para el estudio de fármacos efectivos a la hora de tratar la enfermedad COVID-19 causada por el nuevo coronavirus.
Investigadores de la Universidad Politécnica Federal de Zúrich, en Suiza, descubrieron un importante punto débil del coronavirus causante del COVID-19 con el que se puede inhibir su multiplicación y, con ello, abrir el camino al desarrollo de medicamentos antivirales que aprovechen esa debilidad.
Según informó la televisión suiza RTS, el equipo científico, con colaboración de expertos de las universidades de Berna, Lausana y Cork, en Irlanda, consiguió hallar un método teórico para frenar el mecanismo de producción de proteínas que podría ser la base para futuros fármacos contra el coronavirus SARS-CoV-2.
El freno a la producción de proteínas reduciría la réplica viral del SARS-CoV-2 en células infectadas, un talón de Aquiles hasta ahora desconocido en un coronavirus contra el que muy pocos fármacos se mostraron eficaces, por lo que la ciencia se centró en el desarrollo de vacunas y no tanto en terapias.
Según explican los científicos suizos e irlandeses, su hallazgo se basa en el hecho de que las células producen proteínas mediante uno de sus elementos, el ribosoma, que las sintetiza mediante la lectura del ARN en secuencias de tres letras. Para replicarse en una célula infectada, los virus necesitan que el ribosoma tenga una anomalía en esa lectura del código genético del ARN, denominada cambio de marco (frameshifting), mediante la cual solo lea una o dos letras del ácido ribonucleico en una secuencia.
Tanto el coronavirus causante del COVID-19, como el VIH que provoca el sida, necesitan de estos cambios de marco, en general raros en las células humanas, para reproducirse, por lo que cualquier componente que consiga garantizar que esa lectura incorrecta del ARN nunca se produzca puede debilitar significativamente al virus.
En términos generales, los tratamientos para las infecciones virales pueden dirigirse al virus, el huésped o los síntomas subyacentes de la infección. Los tratamientos antivirales funcionan interrumpiendo el ciclo de vida viral. Para el SARS-CoV-2, el ciclo de vida se puede dividir en tres etapas: entrada y tráfico de la célula huésped, replicación del genoma viral y empaquetamiento y salida de nuevos viriones, apuntaron los investigadores en la revista Science.
Un enfoque antivírico alternativo es, según los científicos, apuntar a las vías de la célula huésped que son esenciales para la replicación del virus, como la síntesis de proteínas. Los virus dependen completamente del anfitrión para la traducción y desarrollaron una variedad de formas de explotar esta maquinaria para su uso. En las células humanas, la traducción se puede dividir en cuatro fases: inicio, alargamiento, terminación y reciclaje del ribosoma.
El estudio reveló este camino a seguir para atacar el virus, aunque no concreta qué componente o fármaco determinado podría eliminar las lecturas incorrectas del ARN, algo que quedaría ahora en manos de investigadores farmacéuticos.
Además, muchos virus dependen de vías de propagación del huésped similares, lo que lleva a que algunos antivirales tengan un amplio espectro de actividad contra múltiples virus. De hecho, en la práctica, muchos de los estudios de fármacos contra el COVID-19 constituyeron lo que se considera una re prueba, es decir, evaluar el uso de drogas ya aprobadas para otros fines -o combinaciones de ellas- para tratar el nuevo coronavirus, lo que sugiere que los antivirales descubiertos en la carrera para tratar COVID-19 pueden ser útiles para futuras epidemias.
A pesar del lanzamiento de vacunas en varios países, el descubrimiento de antivirales para tratar el SARS-CoV-2 sigue siendo importante. Ya existen preocupaciones sobre la aparición de variantes del SARS-CoV-2 que pueden ser menos susceptibles a las vacunas actuales.